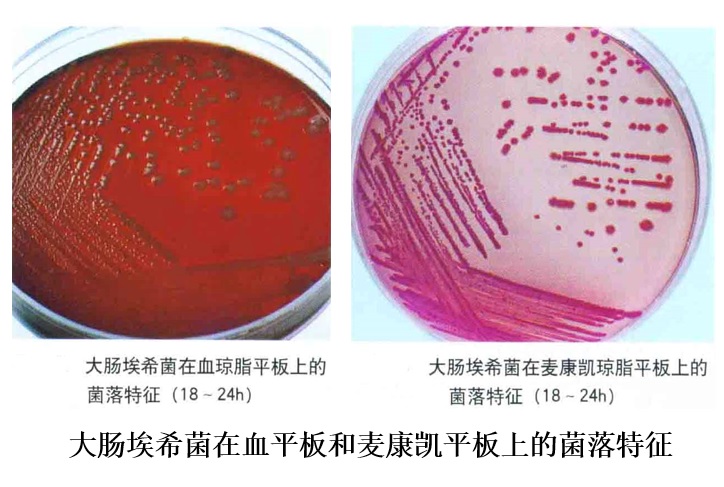
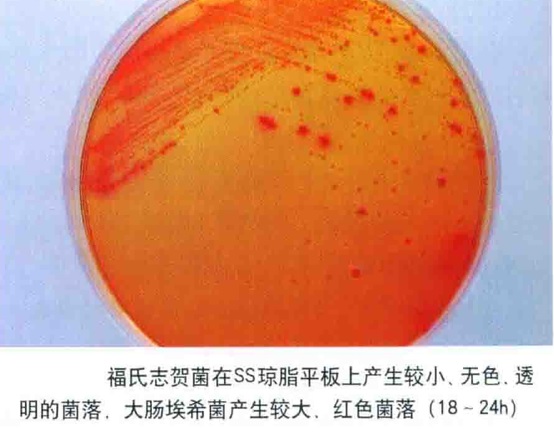
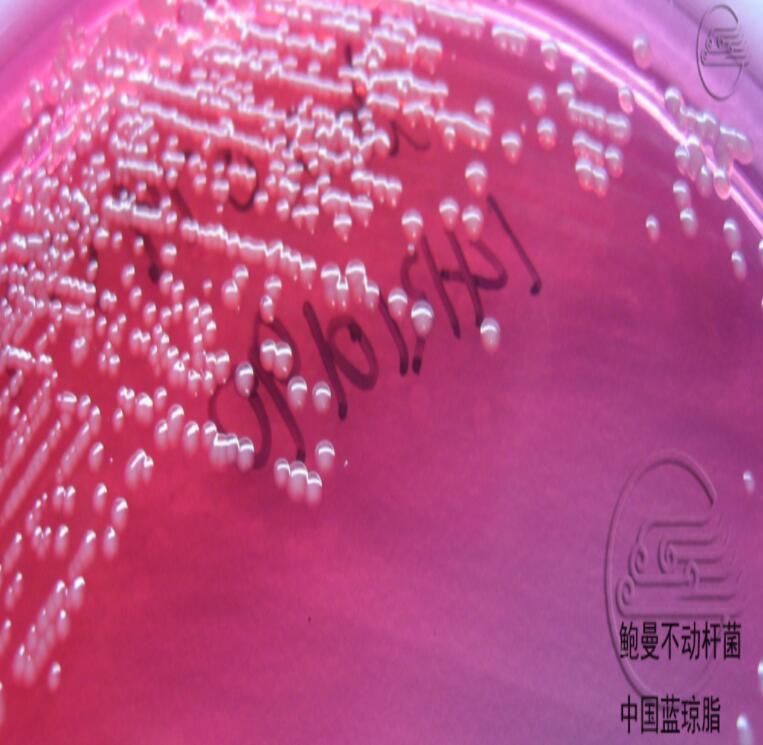
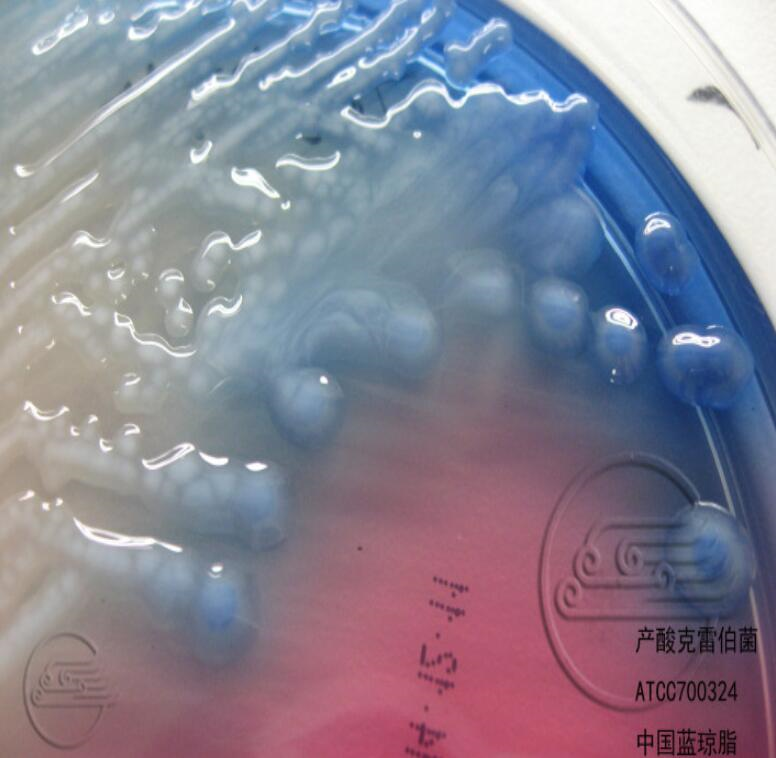
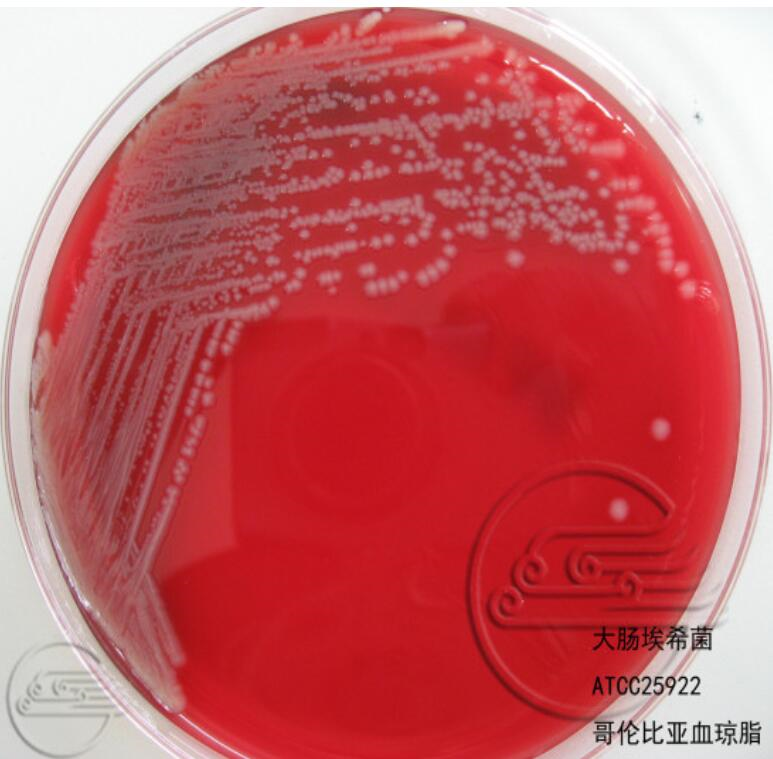
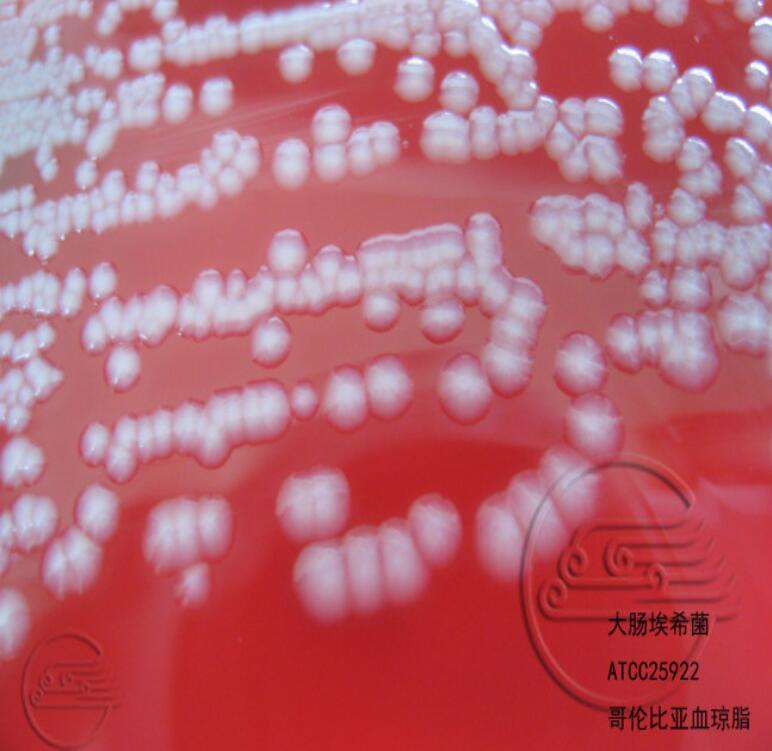
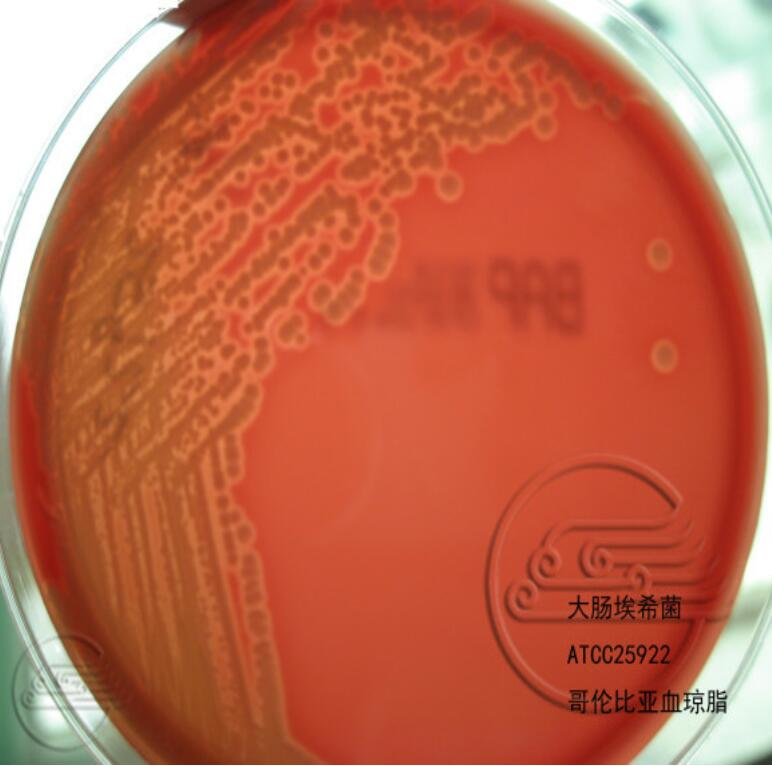
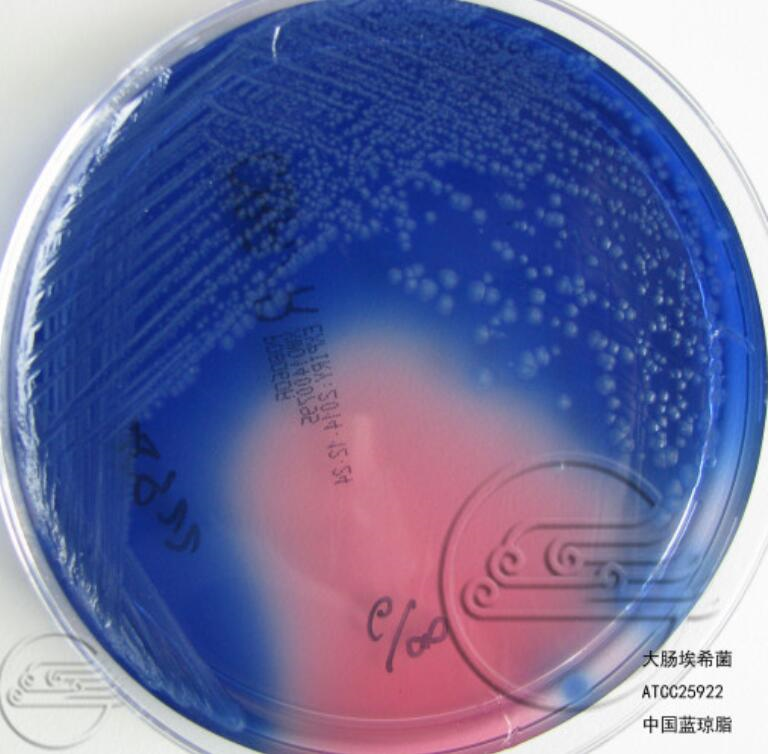
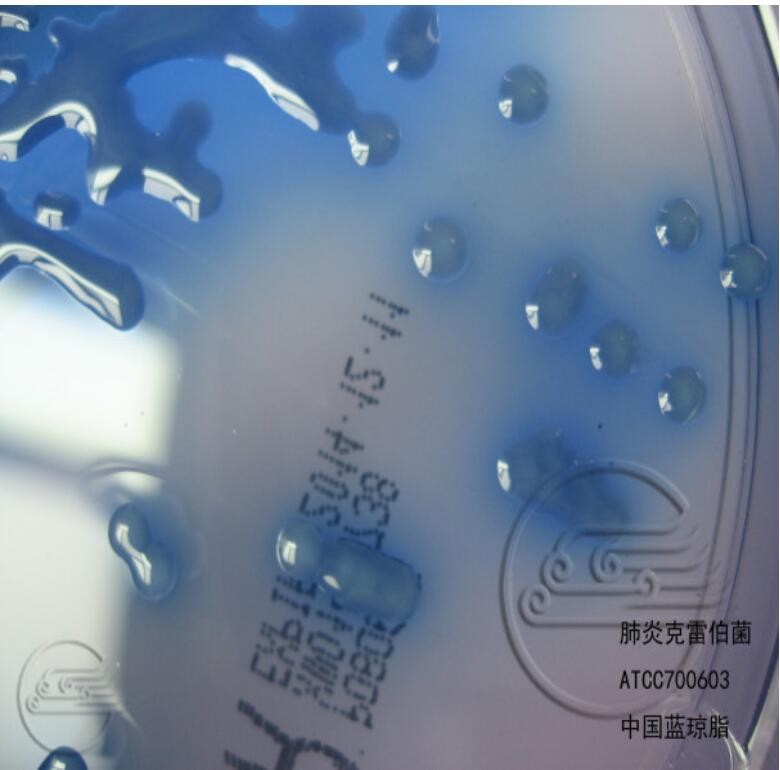
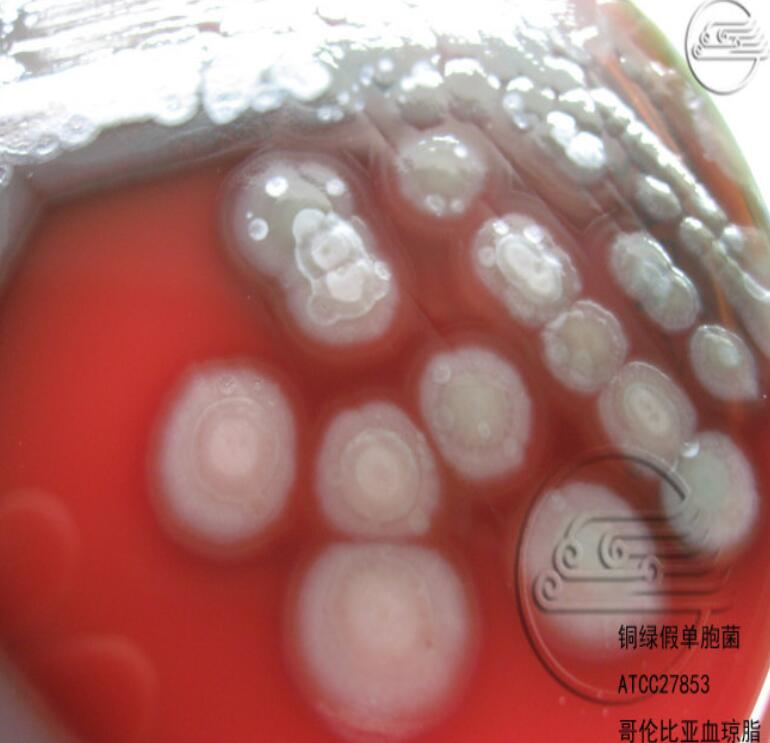
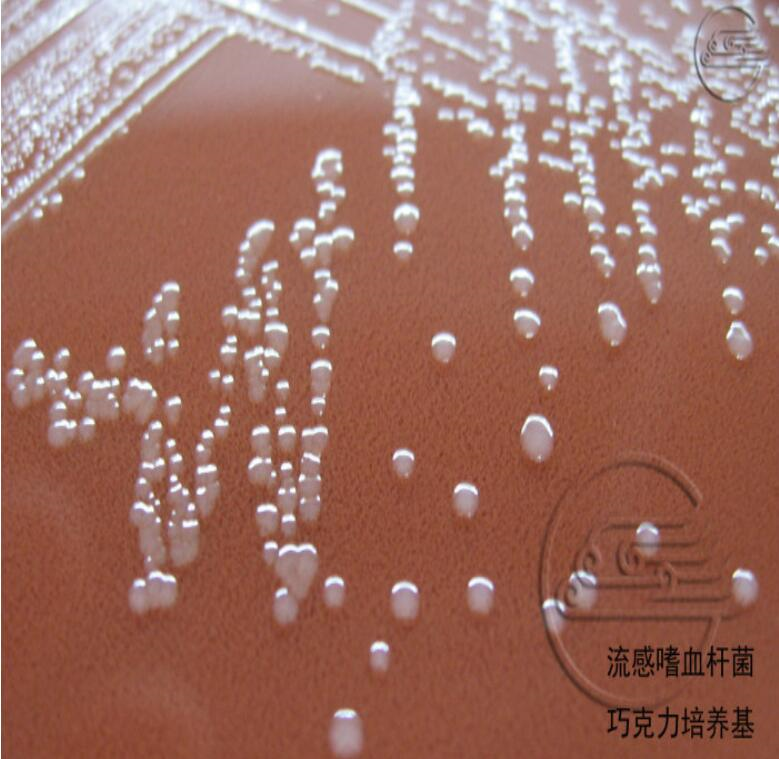

铜绿假单胞菌性角膜炎是一种极为严重的急性化脓性角膜溃疡,发病急,来势猛,病情发展快,潜伏期短(6~24h),角膜溃疡形成迅速,带有黄绿色黏脓性分泌物、前房反应重,常在极短时间内席卷整个角膜而导致毁灭性的破坏。病人感觉眼部剧烈疼痛、羞明流泪,视力急剧减退,后果极其严重,一经发生,必须立即抢救。如未能得到及时有效治疗,大部分角膜将坏死,脱落,导致穿孔,进一步引起眼内炎,甚至全眼球炎。即使溃疡治愈,也可形成粘连性角膜白斑或角膜葡萄肿而导致失明。部分病例经积极抢救而保存眼球后通过角膜移植术,可保存部分视力。
案例1:
患者张某,男,20岁,持续高热8天,大便尚可,偶尔有黏液,食欲缺乏。既往健康。体检:肝脏右肋下50px,脾脏左肋下25px,躯干背侧隐约可见3个米粒大小,压之褪色的淡红色皮疹。血液检查:白细胞未见升高,中性粒细胞占0.70,淋巴细胞占0.30。临床初步诊断为伤寒。采集血液标本送检验科微生物室进行病原学检验。请问:该患者可能为哪种细菌感染?如何进行鉴定?
案例1分析:
分析:该患者可能为伤寒或副伤寒沙门菌感染;细菌学鉴定(略)。
案例2:
患者赵某,女,16岁,某天餐后6小时出现发热,温度达39℃,伴头痛、恶心、腹痛、腹泻。粪便始呈稀泥糊状,后为黏液脓血便,量不多,每天排便十次至数十次不等。你认为最有可能是何菌感染?如何进行细菌学鉴定?
案例2分析:
怀疑为痢疾志贺菌感染;细菌学鉴定(略)。
案例3:
女,22岁,住院一周后出现呼吸道感染症状。检验科采集标本进行细菌培养鉴定后,发现细菌氧化酶试验、硝酸盐还原试验和动力均为阴性,应考虑引起这一感染的是何种细菌?
案例3分析:
依据实验室细菌检查结果氧化酶试验、硝酸盐还原试验和动力均为阴性,应考虑引起这一感染的是不动杆菌,不动杆菌广泛存在于自然界,是引起医院感染的病原菌之一。
案例4:
一名3岁男童在幼儿园进食后,出现严重腹痛和便血。同时进食儿童也有数人出现相同的症状。在治疗中病情加重,又出现肾功能衰竭,临床诊断为出血性结肠炎。最可能的病原菌是?
案例4分析:
最可能的病原菌EHEC,肠出血型大肠埃希菌。该菌感染幼儿为主。
案例5:
患者赵某,女,20岁,某天餐后出现剧烈的腹泻和呕吐,3天后入院,采集粪便送检:粪便呈米泔水样便,做粪便培养,可见平板内出现草绿色环。伴严重脱水,痉挛,血检后发现患者出现代谢性酸中毒,晚间又伴发尿闭。请问:该患者可能为哪种细菌感染?如何鉴定?
案例5分析:
该患者可能为霍乱弧菌的E1Tor型感染。米泔水样便是霍乱感染的特征性大便,而剧烈的腹泻和呕吐是霍乱的表征,做大便培养出现草绿色环是E1Tor型的特征性表现。
肠杆菌科的细菌为革兰阴性杆菌,氧化酶阴性,发酵葡萄糖,硝酸盐还原试验阳性,多数有鞭毛。各菌属种的鉴定鉴别主要利用生化试验与血清学鉴定的手段。肠杆菌科细南多为肠道正常菌群,是医院感染的常见病原菌。
非发酵菌主要是指一群不发酵或不分解糖类的革兰阴性无芽胞需氧杆菌,大多为条件致病菌,也是医院感染的重要病原菌。非发酵菌般通过氧化酶试验、O/F试验、动力及鞭毛菌落色素、硝酸盐还原试验以及在麦康凯琼脂上的生长情况等,可做出初步鉴定。
霍乱弧菌是霍乱的病原菌,在碱性条件下生长,TCBS上形成黄色菌落,可疑菌落应使用01群和0139群霍乱弧菌多价和单价血清进行凝集试验,结合菌落特征和菌体形态,做出初步报告。依据全面生化、血清学分群和分型进行最后的鉴定。副溶血性弧菌具有嗜盐性,生长所需氯化钠的最适浓度为3.5%,主要引起食物中毒。
肠杆菌科、非发酵菌、弧菌科之间可通过氧化酶、0/F试验加以鉴别。
苛养菌对生长环境、营养要求比较苛刻,标本初次培养或次代培养一定要置于CO2,环境,保持一定湿度。
流感嗜血杆菌生长需要X因子、V因子,与金黄色葡萄球菌起在平板上培养时,可出现卫星现象。百日咳鲍特菌可引起百日咳,儿童多见。嗜肺军团菌是医院内感染的病原菌之,医院中央空调冷却塔污染的循环水气溶胶是病菌的主要来限。布鲁菌属是人兽共患感染性疾病的病原菌,常导致实验室获得性感来,应特别注意生物安全防护。幽门螺杆菌为微需氧菌,与人类慢性胃炎胃溃疡和十二指肠溃疡、胃腺癌密切相关。